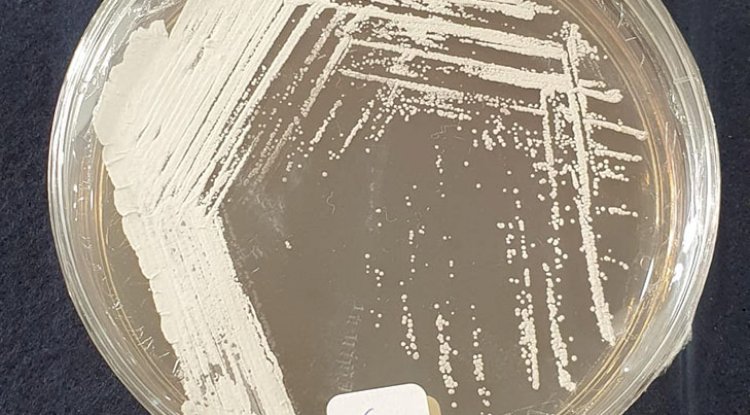

Bioherbicida à base de bactéria da Caatinga pode controlar planta invasora
Por Cristina Tordin, Embrapa Meio Ambiente

Pesquisadores da Embrapa Meio Ambiente e da Universidade de São Paulo (USP), campus de Ribeirão Preto, revelaram uma descoberta promissora para a agricultura: uma bactéria encontrada nos solos da Caatinga demonstrou capacidade de inibir a germinação da buva (Conyza canadensis), uma das plantas daninhas mais resistentes a produtos químicos e de difícil controle do País. A pesquisa identificou na bactéria moléculas naturais com efeito herbicida, abrindo caminho para o desenvolvimento de um bioherbicida inédito, sustentável e adaptado à realidade da produção agrícola brasileira.
O estudo, publicado na revista científica Pest Management Science, foi conduzido pelo químico Osvaldo Ferreira, sob orientação dos pesquisadores da USP Danilo Tosta Souza e Luiz Alberto Beraldo de Moraes, em colaboração com o pesquisador da Embrapa Meio Ambiente Itamar Melo.
A buva é considerada uma das principais inimigas dos agricultores. Presente em praticamente todas as regiões do Brasil, a planta já não responde a diferentes tipos de herbicidas sintéticos. Esse quadro eleva os custos de produção, compromete a produtividade e aumenta o risco de impactos ambientais decorrentes do uso intensivo de defensivos.
Nesse cenário, a busca por alternativas naturais se torna urgente. O uso de microrganismos e de moléculas bioativas produzidas por eles surge como uma estratégia inovadora para reduzir a dependência de químicos sintéticos e oferecer soluções mais sustentáveis no manejo de plantas daninhas.
Diversidade microbiana como fonte de inovação
O ponto de partida da pesquisa foi a triagem de actinobactérias, um grupo de microrganismos conhecidos pela capacidade de produzir compostos bioativos de interesse agrícola e farmacêutico. Vários isolados, oriundos de diferentes biomas brasileiros, foram testados quanto ao potencial de inibir plantas daninhas.
A grande surpresa veio da Caatinga, bioma semiárido caracterizado por condições extremas de temperatura e disponibilidade de água. A cepa Streptomyces sp. Caat 7-52 destacou-se na triagem ao apresentar compostos com forte efeito fitotóxico (prejudicial às plantas).
“A Caatinga pode ser vista como um laboratório natural. Os microrganismos que vivem nesse ambiente desenvolveram estratégias únicas de sobrevivência e, muitas vezes, produzem moléculas inéditas que podem ser aproveitadas para diferentes aplicações”, explica o pesquisador Itamar Melo.
Foto: Danilo Tosta
Foto: Danilo Tosta
A descoberta da albociclina
A análise química revelou dois compostos principais produzidos pela bactéria: o ácido 3-hidroxibenzóico e a albociclina. Essa última foi descrita pela primeira vez com atividade herbicida, representando um avanço inédito no campo da bioprospecção.
Em testes, a albociclina demonstrou ser capaz de inibir a germinação da buva em baixas concentrações (6,25 µg/mL). Esse resultado a coloca como uma candidata promissora para o desenvolvimento de novos bioherbicidas, especialmente porque atua contra uma planta que já não responde bem aos produtos disponíveis no mercado.
“Foi a primeira vez que registramos a atividade fitotóxica da albociclina, e isso amplia significativamente o horizonte de aplicação desse composto. A descoberta pode contribuir para estratégias de manejo mais sustentáveis, que ajudem a reduzir a pressão por uso de herbicidas químicos”, observa Tosta.
Outro diferencial do trabalho foi o uso de técnicas de otimização do meio de cultivo para estimular a produção de albociclina e de seus análogos. Esse ajuste permitiu ampliar a diversidade química das moléculas obtidas e garantir maior rendimento, algo essencial para a futura escalabilidade de um bioherbicida.
Essa abordagem representa um passo estratégico: ao direcionar o metabolismo microbiano, os pesquisadores conseguem não apenas aumentar a quantidade de composto produzido, mas também gerar variantes estruturais que podem apresentar diferentes níveis de atividade biológica.
Caldo da bactéria
Além da extração de moléculas específicas, os cientistas testaram o caldo fermentado bruto da bactéria. O resultado foi igualmente animador: ele apresentou efeito seletivo contra plantas daninhas dicotiledôneas sem a necessidade de processamento químico com solventes. Dicotiledôneas são plantas que, na germinação, apresentam duas folhas embrionárias chamadas cotilédones. Exemplos incluem plantas daninhas como buva, caruru e picão-preto, e culturas agrícolas como feijão, amendoim e algodão.
Na prática, isso significa que o microrganismo pode ser usado de forma mais simples e com menor custo, reduzindo etapas de purificação e favorecendo o desenvolvimento de um produto mais acessível ao agricultor. Ao mesmo tempo, a solução é ambientalmente mais limpa, uma vez que dispensa o uso de solventes industriais, explica Beraldo.
Os próximos passos da pesquisa envolvem a realização de testes em condições de campo, a avaliação da eficácia em diferentes culturas, o desenvolvimento de formulações comerciais e ecotoxicologia, estudos sobre os efeitos dos metabólitos em organismos vivos não alvo. O objetivo é integrar a tecnologia a programas de Manejo Integrado de Plantas Daninhas (MIPD), que combinam diferentes práticas para manter o equilíbrio entre produtividade e sustentabilidade.
“Estamos ainda em uma fase inicial, mas os resultados são muito promissores. O desafio agora é transformar esse potencial em uma solução prática para os agricultores, que possa ser usada em larga escala”, afirma Melo.
O potencial dos biomas brasileiros
A descoberta reforça a importância de investir na bioprospecção de microrganismos nativos dos biomas brasileiros. A Caatinga, frequentemente lembrada apenas por sua fragilidade ecológica, mostra-se também um reservatório de biodiversidade microbiana capaz de gerar inovações estratégicas para a agricultura.
A identificação de compostos bioativos como a albociclina fortalece a posição do Brasil como protagonista no desenvolvimento de bioinsumos agrícolas. Além de reduzir a dependência de insumos importados, especialmente no setor de herbicidas, a aposta em soluções naturais contribui para a construção de uma agricultura mais verde, resiliente e alinhada às demandas globais de sustentabilidade.
Com o País figurando entre os maiores consumidores de herbicidas do mundo, avanços como esse são considerados estratégicos para garantir a competitividade do agronegócio brasileiro. Ao mesmo tempo, oferecem caminhos para reduzir impactos ambientais e responder à crescente pressão por práticas agrícolas de baixo carbono.
“Esse é um exemplo de como a ciência pode transformar a biodiversidade brasileira em soluções inovadoras. A Caatinga guarda um potencial enorme, e estamos apenas começando a explorá-lo”, conclui Tosta.

Foto: Fernanda Birolo









